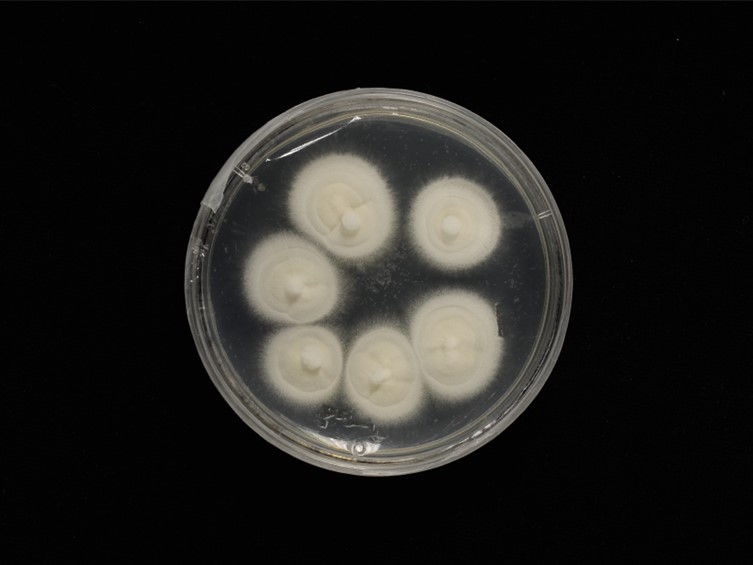

Holotype:
THAILAND, Phetchabun Province, Nam Nao National Park, 24 Nov. 2016, S. Mongkolsamrit, K. Tasanathai, P. Srikitikulchai, S. Wongkanoun, U. Pinruan, R. Promharn, holotype BBH 42334, ex-type living culture BCC 83036.
Habitat:
Unidentified dicotyledonous leaves.
Host:
Ant.
Description:
Mycophylic on Ophiocordyceps camponoti-leonardi (Ophiocordycipitaceae) attached to unidentified dicotyledonous leaves of forest plants.  Mycelium white. Conidial structures consisting of erect conidiophores usually arising from prostrate mycelium, verticillate with phialides in whorls of two to five on each branch. Conidiogenous cells phialides, gradually tapering from base to the apex, 10-25 × 1-2 μm. Conidia hyaline, oblong-ellipsoidal or ellipsoidal, smooth, aseptate, 3-6 × 1-2 μm, aggregated in heads at the apex of phialides. Sexual morph not observed.
Mycelium white. Conidial structures consisting of erect conidiophores usually arising from prostrate mycelium, verticillate with phialides in whorls of two to five on each branch. Conidiogenous cells phialides, gradually tapering from base to the apex, 10-25 × 1-2 μm. Conidia hyaline, oblong-ellipsoidal or ellipsoidal, smooth, aseptate, 3-6 × 1-2 μm, aggregated in heads at the apex of phialides. Sexual morph not observed.
Culture characteristics:
Colonies on PDA reaching 8–12 mm diam after 7 d at 25 °C. Colonies compact with white mycelium, reverse uncoloured. Conidia and reproductive structures not observed.
Colonies on PDA reaching 8–12 mm diam after 7 d at 25 °C. Colonies compact with white mycelium, reverse uncoloured. Conidia and reproductive structures not observed.
Reference:
Crous PW, Cowan DA, Maggs-Kölling G, et al. (2021). Fungal Planet description sheets. Persoonia 46: 504–505.
DOI: https://doi.org/10.3767/persoonia.2021.46.11Species |
Strain |
Compound |
Pubchem CID |
Biological activity |
Reference |
|---|
|
Strain |
ITS | LSU | RPB1 | TEF1 |
|---|---|---|---|---|
| BCC 83036 | MW620992 | MW621499 | MW603489 | MW603488 |